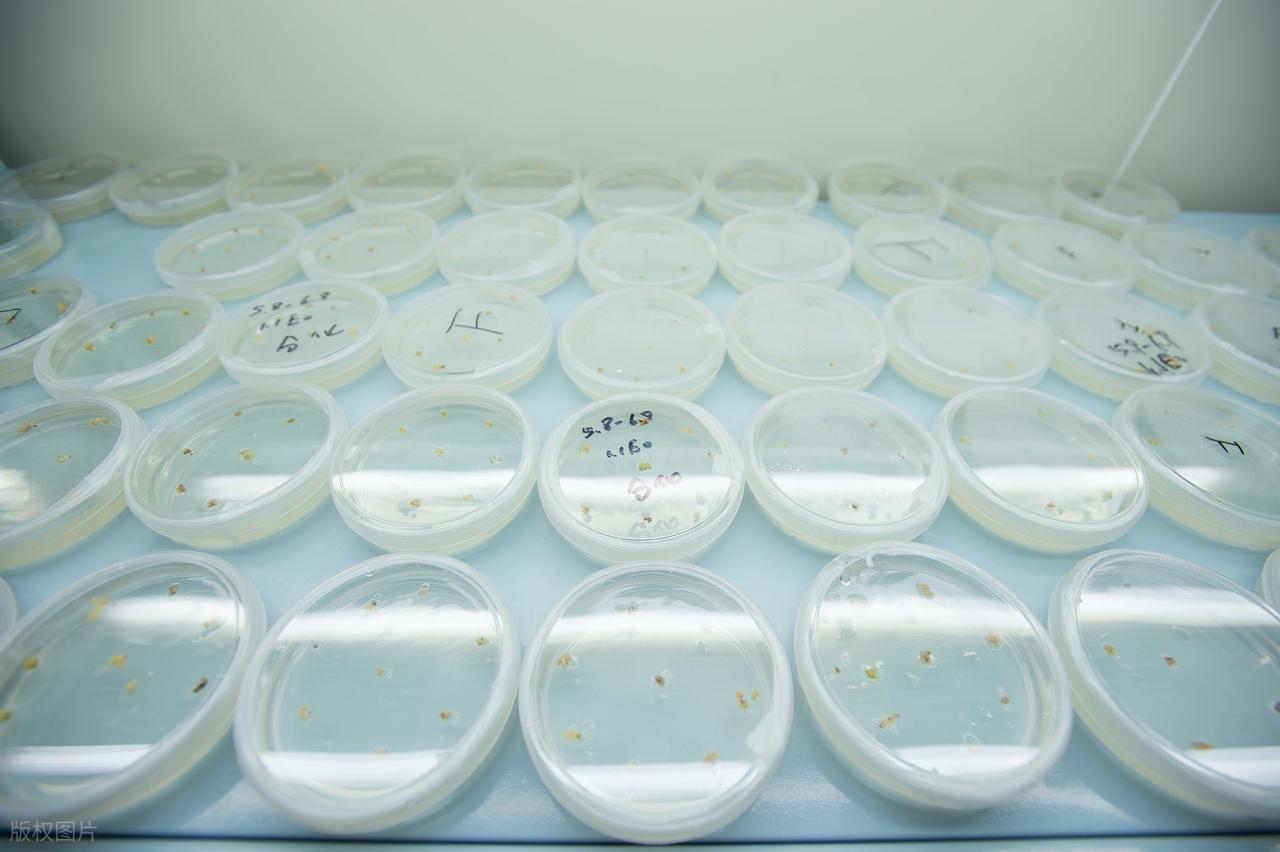

合成生物到底能颠覆什么?变局TheChanges
未来如果说还有什么科技能颠覆传统产业的,目前大多数人还没听过的合成生物算一个。药明康德为此砸几十亿建全球最大的合成生物CDMO基地,红杉、高瓴等顶级资本,过去3年在这个赛道投了超千亿,巴斯夫、万华化学这种传统巨头,都纷纷跨界布局。
合成生物到底是什么?它就是一场“造物革命”。传统的制造,是从自然界里找原料、靠化学合成造东西。而合成生物,是像程序员写代码一样,编辑微生物的基因,把细菌、酵母变成一个个“微型工厂”,让它们直接生产出我们想要的任何东西——小到一款新药、医美原料,大到化工材料、航空燃油,甚至人造肉、粮食,都能造出来。
合成生物与传统生物医药,成本天差地别很多人把合成生物归为生物医药的分支,这完全是低估了它的颠覆性。
它和传统生物医药,从底层逻辑上就是两码事。
传统生物医药的研发,本质是“筛选”。做小分子药,要从几十万种化合物里筛出能治病的成分;做抗体药,要靠细胞培养一点点优化,研发周期动辄10年,投入几十亿,失败率还超过90%。
合成生物则是“精准设计”,可以直接编辑基因,让微生物精准生产出想要的药物分子,甚至能设计出传统技术根本做不出来的复杂结构。
就拿胰岛素来说,最早传统方法要从几吨猪胰腺里提取几克,普通人根本用不起;而用合成生物改造的大肠杆菌,就能批量生产,成本能骤降90%以上,直接让胰岛素成了普惠药。这也是合成生物与传统生物医药的最大差别,也就是成本和效率,完全是天壤之别。
传统生物医药,不管是化学合成还是生物提取,都面临高污染、高耗能、低收率的问题。很多高端药的合成,要十几步甚至几十步化学反应,每一步都有损耗,最终收率可能不到1%,成本自然居高不下。
合成生物的“微生物工厂”,常温常压下就能生产,一步到位,收率能做到90%以上,能耗和污染比传统化工少90%,成本能降50%以上。
合成生物工厂的扩产极其简单,只要把发酵罐放大,就能从实验室小试,做到万吨级量产,这是传统生物医药根本比不了的。
合成生物的应用远比生物医药广虽然名字上是生物,但合成生物产业几乎能运用到所有需要“材料”的产业。
传统生物医药,核心局限在医疗健康领域,天花板再高,也是一个细分行业。
合成生物真正颠覆的,是“造物”的逻辑,原先所有需要各种加工的原材料,都可以改由微生物产出,也改变了制造的底层基础。
它的应用场景覆盖医药、化工、农业、食品、能源、环保,几乎所有你能想到的制造业,都能被它重构。
比如医美圈火到出圈的玻尿酸、胶原蛋白,现在主流的生产方式都是合成生物,我们用的塑料,可以不再从石油中加工产出,而是由微生物直接产出可降解的塑料分子。农业里的农药、化肥,都能靠合成生物的微生物做出更环保、更高效的替代品。
巨头和资本,大举布局面对合成生物这样的造物革命,巨头和资本将其看成是是万亿级甚至十万亿级的超级市场。业内测算,未来10年,全球60%以上的化学品、材料、药品,都可以用合成生物的方式生产,最先开始重磅投入的也是传统化工巨头巴斯夫,这种布局未来化工替代品的逻辑足以说明行业的前景。
有投资机构测算,仅在中国,合成生物的市场规模,5年内就会突破万亿。长期来看,它会重构整个制造业的格局,诞生一批比现在的新能源巨头、医药巨头体量更大的公司。
特别是在碳中和的大背景下,合成生物是唯一的解。传统化工、制造业,是碳排放和污染的大户,而全球双碳目标下,高耗能、高污染的产业必然要被淘汰。合成生物是靠微生物产出,几乎没有有害排放,是绿色制造模式,完美契合碳中和的要求。
产业到成熟,大机会到底还要等多久?目前看,合成生物的未来是确定的,但现在的市场,一半是真技术,一半是炒概念。
短期3-5年是可以出现细分赛道的商业化爆发期。现在合成生物已经能落地赚钱的,是高附加值、小批量的细分领域,比如医药中间体、医美原料、高端食品添加剂、特殊酶制剂。这些领域技术成熟度高,审批难度小,规模化门槛低,会先跑出一批能稳定盈利、有核心技术的公司,也是现在最确定的机会。
全行业渗透的爆发期可能还需要5-10年。合成生物在这个阶段会突破技术瓶颈,从高附加值的小众领域,向大宗化工品、农业育种、生物能源这些万亿级的大市场渗透。当合成生物生产的大宗材料,成本能比传统化工更低的时候,整个产业会迎来井喷式爆发,真正重构全球制造业的格局。
目前国内已经有企业在稳定的扩产扩规模,以达到降低产业化成本的目的,这部分消息可能会在下半年或者明年从资本市场体现出来。
真正的合成生物产业,笔者展望未来会变成像今天的互联网、电力一样的底层基础设施,渗透到我们衣食住行的每一个角落,彻底改变我们的生产和生活方式。这个时间可能需要10-20年或者更长。